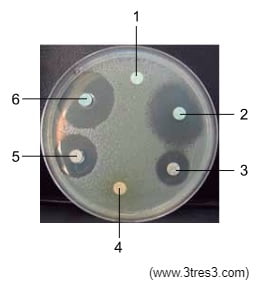

Questões sobre Reino Monera
01) (FCMMG/2024) Na agricultura, a utilização de fertilizantes naturais compreende o uso de bactérias nitrificantes que ligadas às raízes de determinadas plantas captam o nitrogênio da atmosfera que é assimilado pela planta. O processo é chamado de fixação biológica de nitrogênio e é considerado o mais importante processo biológico do planeta, depois da fotossíntese. As bactérias benéficas colonizam as células dentro dos nódulos radiculares das raízes da planta, convertendo o nitrogênio atmosférico em amônia.
EMBRAPA. Fixação biológica de nitrogênio. Disponível em: https://www.embrapa.br/tema-fixacao-biologica-de-nitrogenio.
Acesso em: 25 maio 2023.
As bactérias nitrificantes que participam do processo são exemplos de
A) bactérias quimioautotróficas.
B) bactérias fotoautotróficas.
C) bactérias quimio-heterotróficas.
D) bactérias foto-heterotróficas.
02) (F.M.Olinda/2019-2) Certas bactérias apresentam uma cobertura externamente à parede celular, formada por polissacarídeos e proteínas, conhecida por cápsula bacteriana. Algumas espécies de linhagem capsuladas como, por exemplo, as bactérias Streptococcus pneumoniae causam pneumonia, enquanto outras bactérias, que são de linhagem não capsuladas, são incapazes de causar a doença. Isso se deve porque a cápsula permite que o micro-organismo:
A) Tenha uma reprodução sexuada mais eficiente.
B) Não seja fagocitado e destruído por glóbulos brancos.
C) Tenha uma melhor movimentação da célula dentro do organismo humano.
D) Destrua substâncias tóxicas, como antibióticos, através dos genes presentes na cápsula.
03) (Pequeno Príncipe/2016) Leia o texto a seguir, publicado na revista Superinteressante
O que arde nem sempre cura
A água oxigenada prejudica a cicatrização de um corte? Sim. No geral, o melhor é deixar o corpo cuidar sozinho do fechamento do talho. Basta limpar bem o local com água ou soro fisiológico, receita a cirurgiã plástica Lydia Massako Ferreira, da Universidade Federal de São Paulo. A ideia, muito difundida, de que substâncias que fazem a pele arder são boas para a cicatrização é errada. Elas agridem quimicamente a ferida e só devem ser usadas se há risco de infecção, aconselha Lydia. Assim, um corte com lâmina ou um joelho ralado no cimento não precisam mais do que uma boa lavada. A água oxigenada atrapalha a formação das fibras de colágeno que vão preencher o corte, avisa a dermatologista Núbia Rossetti. Ferimentos feitos com objetos enferrujados pedem cuidado maior. Nesses casos, a água oxigenada e outros antissépticos ajudam, mas deve ser avaliada a necessidade também de uma vacina antitetânica. Todas essas substâncias devem ser usadas, com certeza, quando já existe infecção, pois matam os microrganismos.
Disponível em: <https://super.abril.com.br/comportamento/o-que-arde-nem-sempre-cura>. Acesso em: 06/05/2016.
O texto relata que o uso de água oxigenada (peróxido de hidrogênio) em ferimentos não é interessante, pois sua oxidação poderia roubar elétrons das moléculas de colágeno produzidas pelos fibroblastos, atrapalhando a cicatrização do ferimento. Ainda assim, muitas pessoas utilizam a água oxigenada em ferimentos, buscando seu poder antisséptico. A água oxigenada possui essa ação porque
A) a reação química promovida pela catalase decompõe o peróxido de hidrogênio e isso afeta as bactérias anaeróbias.
B) os peroxissomos bacterianos não toleram a presença do peróxido de hidrogênio e isso leva à morte bacteriana.
C) a decomposição química do peróxido de hidrogênio acidifica a região, levando as bactérias aeróbicas à morte.
D) a catalase bacteriana decompõe a água oxigenada e o oxigênio liberado oxida a parede celular da bactéria,destruindo-a.
E) o peróxido de hidrogênio é uma substância existente no sistema imunológico e é sinalizadora para que macrófagos fagocitem as bactérias do ferimento.
04) (CULTURA INGLESA/2014.2) Antibiogramas são exames de diagnóstico que conseguem testar a sensibilidade da bactéria causadora a infecção em um indivíduo e, consequentemente, o antibiótico mais indicado para o seu tratamento. Para obter um antibiograma, uma suspensão de bactérias de cultivo recente é inoculada na superfície de uma placa de ágar, à qual são adicionados discos de papel impregnados com concentrações iguais de antibióticos. Após a incubação em estufa, analisa-se o padrão de crescimento ou inibição ao redor de cada disco.
(www.interlabdist.com.br. Adaptado.)
A figura mostra o resultado de um antibiograma obtido na investigação de uma rinite causada por bactérias.
De acordo com os resultados mostrados no antibiograma, os antibióticos mais indicados para o tratamento dessa rinite são
A) 1 e 4
B) 2 e 6
C) 3 e 5
D) 2 e 3
E) 5 e 6
05) (UECE/2016.2) As bactérias são seres unicelulares, procariotos, que têm formas de vida do tipo isolada ou em agrupamentos variados do tipo coloniais. Embora esses seres celulares sejam considerados pelo senso comum como “micróbios perigosos”, há muitas espécies importantes para o equilíbrio dinâmico dos seres vivos e destes com o meio ambiente. Assim sendo, muitos estudos e pesquisas são desenvolvidos na área da microbiologia, para melhor conhecer a maquinaria biológica das bactérias.
Sobre a citologia bacteriana, é correto afirmar que
A) moléculas de DNA que ficam ligadas ao cromossomo bacteriano e costumam conter genes para resistência a antibióticos são denominadas de plasmídeos.
B) o capsídeo bacteriano, também conhecido como membrana celular, é constituído por substância química, exclusiva das bactérias, conhecida como mureína.
C) os pneumococos, bactérias causadoras de pneumonia, são espécies de bactérias que possuem, externamente à membrana esquelética, outro envoltório, mucilaginoso, denominado de cápsula.
D) externamente à membrana plasmática existe uma parede celular ou membrana esquelética, de composição química específica de bactérias — o ácido glicol.
06) (FUVEST) Considere as seguintes características atribuídas aos seres vivos:
I. Os seres vivos são constituídos por uma ou mais células.
II. Os seres vivos têm material genético interpretado por um código universal.
III. Quando considerados como populações, os seres vivos se modificam ao longo do tempo.
Admitindo que possuir todas essas características seja requisito obrigatório para ser classificado como “ser vivo”, é correto afirmar que
A) os vírus e as bactérias são seres vivos, porque ambos preenchem os requisitos I, II e III.
B) os vírus e as bactérias não são seres vivos, porque ambos não preenchem o requisito I.
C) os vírus não são seres vivos, porque preenchem os requisitos II e III, mas não o requisito I.
D) os vírus não são seres vivos, porque preenchem o requisito III, mas não os requisitos I e II.
E) os vírus não são seres vivos, porque não preenchem os requisitos I, II e III.
07) (UFG) As bactérias, ao se reproduzirem assexuadamente, originam dois indivíduos do mesmo tamanho e geneticamente idênticos. Já alguns levedos, para se reproduzirem, emitem uma pequena expansão na superfície da célula, que cresce e posteriormente se destaca, formando um novo indivíduo também geneticamente igual. Os dois tipos de reprodução descritos são, respectivamente,
A) cissiparidade e conjugação.
B) cissiparidade e brotamento.
C) fragmentação e gemiparidade.
D) conjugação e esporulação.
E) conjugação e cissiparidade.
08) (PISM-UFJF) “A presença de cianotoxinas em mananciais de abastecimento público tem se tornado um problema crescente no Brasil e existe uma preocupação, tanto dos governantes quanto da opinião pública, de que estas toxinas possam afetar a saúde humana, seja através do consumo de água contaminada, seja através do consumo de pescado. A ocorrência de casos de contaminação de humanos por água de abastecimento público já é um fato no Brasil, como a tragédia ocorrida em Caruaru (PE) em 1996 e um episódio de intoxicação de pacientes de hemodiálise no Rio de Janeiro em 2001”.
FERRÃO-FILHO. A.S. et al. Florações de cianobactérias tóxicas no Reservatório do Funil: dinâmica sazonal e consequências para zooplâncton. Oecologia brasiliensis, Rio de Janeiro, v. 13, n. 2, p. 346-365, fev. 2009.
As cianotoxinas são substâncias tóxicas produzidas por cianobactérias. Sobre cianobactérias, é CORRETO afirmar que
A) são sempre organismos marinhos.
B) não fixam nitrogênio, pois não habitam os solos.
C) são autótrofas fotossintetizantes, com clorofila a como pigmento principal.
D) estão incluídas no Reino Plantae, uma vez que cianobactérias ancestrais deram origem aos vegetais terrestres.
E) são organismos eucariontes autótrofos.
09)(PUC-RS/2015) Pesticidas do tipo bactericidas destroem procariotos por meio de diversos mecanismos: afetando a estrutura de _________, o agente inibe a formação da parede celular; destruindo _________, a toxina impede diretamente a síntese proteica; e, alterando enzimas transcricionais, a droga bloqueia a formação imediata de _________.
A) desmossomos – íntrons – RNA.
B) desmossomos – ribossomas – ATP.
C) glicocálix – fosfolipídeos – dupla hélice.
D) peptidoglicanos – ribossomas – RNA.
E) peptidoglicanos – fosfolipídeos – dupla hélice.
10) (UFSC/2020) Bactérias da espécie Klebsiella pneumoniae são capazes de resistir aos fármacos mais potentes para o tratamento de infecções graves e estão entre os micro-organismos que mais causam infecções hospitalares. Ao caracterizar 48 colônias de K. pneumoniae de pacientes ambulatoriais com infecção do trato urinário do município de Ribeirão Preto, localizado no Sudeste do Brasil, o estudo identificou cepas com perfil genético característico daquelas que provocam infecção hospitalar. Os resultados aumentam a preocupação sobre a vigilância epidemiológica relacionada à colonização em pacientes que recebem alta hospitalar, a fim de prevenir a ocorrência e a disseminação de infecções bacterianas multirresistentes na comunidade
AZEVEDO, P A A FURLAN, J P R GONÇALVES, G B GOMES, C N GOULART, R S STEHLING, E G PITONDO
SILVA, A Molecular characterisation of multidrug resistant Klebsiella pneumoniae belonging to CC 258 isolated from outpatients
with urinary tract infection in Brazil Journal of Global Antimicrobial Resistance, v 18 p 74 79 2019
Sobre bactérias, é correto afirmar que:
01. as cianobactérias apresentam cloroplastos com a capacidade de realizar a fotossíntese bacteriana, o que auxilia a produção de oxigênio atmosférico.
02. a conjugação bacteriana é um processo de ganho de variabilidade, via recombinação entre duas bactérias (doadora e receptora), que pode promover resistência a determinado fármaco.
04. a parede celular das bactérias tem na sua composição peptidoglicano, uma gordura que possui capacidade impermeabilizante e que torna as bactérias resistentes aos antibióticos.
08. sua principal forma de reprodução é assexuada por brotamento, como na espécie Escherichia coli, presente no sistema digestório humano.
16. bactérias de várias formas podem unir-se e formar associações coloniais; destacam-se as colônias de bactérias espiroquetas, causadoras da tricomoníase.
32. seu material genético é constituído de DNA circular, disperso no citoplasma sem nenhuma membrana protetora.
Soma =
11) (UEA/2018) A ciclagem da matéria pode ser realizada por diversos seres vivos presentes na água e no solo. Eles conseguem transformar a matéria orgânica em matéria inorgânica, que pode ser utilizada pelos produtores que integram as cadeias alimentares.
Os microrganismos aos quais o texto se refere são
A) os vírus e as algas.
B) os vermes e as moscas.
C) os protozoários e as minhocas.
D) as bactérias e os fungos.
E) as algas e as bactérias.
12) (UDESC/2018) “Escherichia coli é comum na flora bacteriana do intestino de humanos e de outros animais, mas que em grandes quantidades pode causar problemas como infecção intestinal e infecção urinária, acontecendo principalmente se o indivíduo consumir água ou alimentos contaminados”.
Fonte: KAPER JB, NATARO JP, MOBLEY HLT. Pathogenic Escherichia coli. Nat. Rev. Microbiol., 2: 123-140, 2004
A respeito das bactérias, assinale a alternativa incorreta.
A) Algumas bactérias possuem metabolismos aeróbico, na presença de oxigênio, e outras anaeróbicas, condição sem oxigênio.
B) Apenas uma pequena porcentagem das espécies de bactérias causa doenças ao homem.
C) As bactérias são unicelulares e procariontes e podem viver em formas isolada ou colonial.
D) Bactérias são seres pluricelulares e eucariontes que podem sintetizar diferentes componentes químicos do meio ambiente ou de seus hospedeiros.
E) Na atual classificação dos organismos, a bactéria E. coli está contida no domínio Bactéria.
13) (Facig/2018) As bactérias são seres procariontes e unicelulares e se caracterizam por não possuírem carioteca. Os únicos
organoides citoplasmáticos são os ribossomos que estão relacionados à síntese de proteínas. Além disso, as bactérias apresentam um pequeno segmento circular que contém diversos genes, como alguns que conferem resistência a antibiótico. Esse segmento é conhecido nas bactérias por:
A) Capsídeo.
B) Nucleoide.
C) Plasmídeo.
D) Mesossomo.
Gabarito das Questões comentadas sobre Reino Monera
01) As bactérias que participam do ciclo do nitrogênio utilizam energia liberada nos processos oxidativos do ciclo para produção de matéria orgânica; são, portanto, quimioautotróficas.
Resp.: A
02) A presença da cápsula bacteriana dificulta a fagocitose pelas células de defesa; consequentemente, a bactéria apresenta maior poder patogênico.
Resp.: B
03) Com a degradação da água oxigenada ocorre liberação de gás O2, letal para as bactérias anaeróbias estritas como, por exemplo, a bactéria causadora do tétano (Clostridium tetani).
Resp.: A
04) Os halos escuros representam lugares onde as bactérias não se desenvolveram. Assim, analisando os resultados da placa, os antibióticos mais eficientes foram o de número 2 e o de número 6.
Resp.: B
05) Em certas bactérias, além do cromossomo bacteriano, pode haver um DNA extracromossômico, denominado plasmídeo. Ele não contém genes essenciais à bactéria, mas, possui genes relacionados à resistência a antibióticos. Contudo, o plasmídeo não se encontra associado ao DNA bacteriano.
Em algumas bactérias, externamente à parede celular (membrana esquelética), encontra-se um outro revestimento (mucilaginoso), chamado de cápsula. De um modo geral, a presença de cápsula confere maior patogenicidade às bactérias.
Resp.: C
06) Os vírus são organismos acelulares, logo, não se enquadram no item I. Tanto vírus como bactérias possuem um material genético e sofrem mutações. Assim, os itens II e III são válidos tanto para vírus como para bactérias, enquanto o item I é válido somente para bactérias.
Resp.: C
07) A forma de reprodução bacteriana descrita no texto é a cissiparidade (divisão binária simples). Já o processo citado, que ocorre em leveduras, é o brotamento, um processo assexuado que se caracteriza pela formação de um broto lateral.
Resp.: B
08) As cianobactérias são organismos procariontes, autótrofos. Possuem clorofila a como principal pigmento fotossintetizante. Esse pigmento localiza-se em dobras da membrana, chamadas lamelas, dispostas no citoplasma.
Resp.: C
09) A parede celular das bactérias é constituída por peptoglicanos (açúcares + poucos aminoácidos). Muitos antibióticos atuam em nível de ribossomos, inibindo a síntese de proteínas bacterianas, muitas das quais, integrantes da parede celular.
Resp.: D
10) Estão corretos os itens 02 e 32. Soma = 34
01. As cianobactérias são organismos procariotos, logo, não possuem cloroplastos.
04. O peptideoglicano é uma mescla de aminoácidos + açúcares; não uma gordura. Essa parede protege a célula contra agentes do meio e evita que a célula bacteriana estoure (por variação osmótica).
08. A principal forma de reprodução bacteriana é assexuada, por cissiparidade (fissão binária).
16. As formas coloniais ocorrem com cocos e bacilos, não ocorrendo com espiroquetas.
11) O texto faz menção à decomposição da matéria orgânica, com a consequente ciclagem dos nutrientes, função desempenhada pelas bactérias e pelos fungos.
Resp.: D
12) As bactérias são seres unicelulares e procariontes.
Resp.: D
13) O plasmídeo corresponde a um DNA extra, presente em certas bactérias, que não contém genes essenciais à sobrevivência da bactéria. Contudo, no plasmídeo, há alguns genes relacionados com a resistência a antibióticos.
Resp.: C
NOTA DE CORTE SISU
Clique e se cadastre para receber as notas de corte do SISU de edições anteriores.




Excelentes questões parabéns